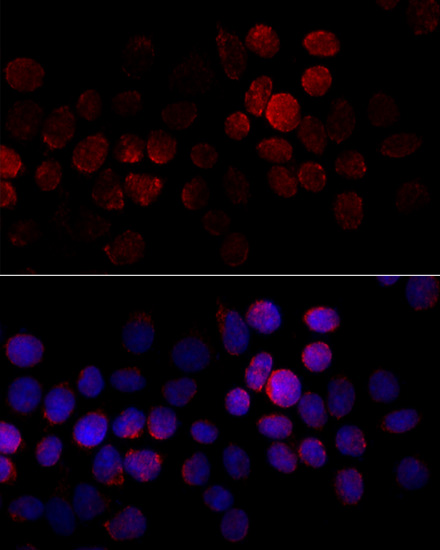
Immunofluorescence - CYP2J2 Polyclonal Antibody

-
Product Name
CYP2J2 Polyclonal Antibody
- Documents
-
Description
Polyclonal antibody to CYP2J2
-
Tested applications
IF
-
Species reactivity
Human
-
Alternative names
CYP2J2 antibody; CPJ2 antibody; CYPIIJ2 antibody; cytochrome P450 2J2 antibody
-
Isotype
Rabbit IgG
-
Preparation
Antigen: A synthetic peptide corresponding to a sequence within amino acids 200-300 of human CYP2J2 (NP_000766.2).
-
Clonality
Polyclonal
-
Formulation
PBS with 0.02% sodium azide, 50% glycerol, pH7.3.
-
Storage instructions
Store at -20℃. Avoid freeze / thaw cycles.
-
Applications
IF 1:50 - 1:200
-
Validations
Immunofluorescence - CYP2J2 Polyclonal Antibody
Immunofluorescence analysis of HeLa cells using CYP2J2 antibody at dilution of 1:100 (40x lens). Blue: DAPI for nuclear staining.
-
Background
Metabolizes arachidonic acid predominantly via a NADPH-dependent olefin epoxidation to all four regioisomeric cis-epoxyeicosatrienoic acids. One of the predominant enzymes responsible for the epoxidation of endogenous cardiac arachidonic acid pools. Catalyzes the monooxygenation of a various compounds, such as danazol, amiodarone, terfenadine, astemizole, thioridazine, tamoxifen, cyclosporin A and nabumetone. Catalyzes hydroxylation of the anthelmintics albendazole and fenbendazole. Catalyzes the sulfoxidation of fenbedazole.
Related Products / Services
Please note: All products are "FOR RESEARCH USE ONLY AND ARE NOT INTENDED FOR DIAGNOSTIC OR THERAPEUTIC USE"
